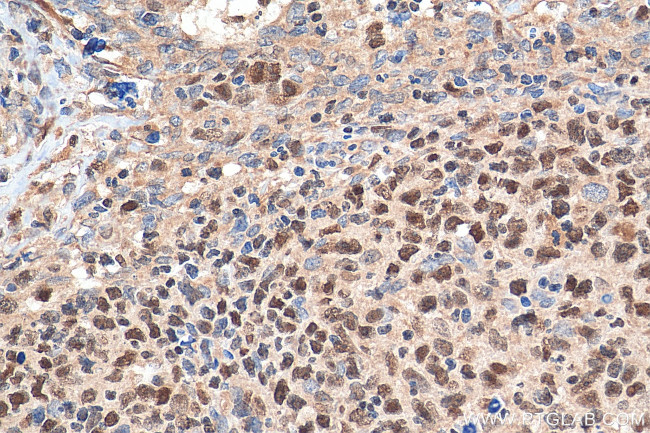
IKZF1 Antibody in Immunohistochemistry (Paraffin) (IHC (P))

Search
Proteintech
IKZF1 Polyclonal Antibody
{{$productOrderCtrl.translations['antibody.pdp.commerceCard.promotion.promotions']}}
{{$productOrderCtrl.translations['antibody.pdp.commerceCard.promotion.viewpromo']}}
{{$productOrderCtrl.translations['antibody.pdp.commerceCard.promotion.promocode']}}: {{promo.promoCode}} {{promo.promoTitle}} {{promo.promoDescription}}. {{$productOrderCtrl.translations['antibody.pdp.commerceCard.promotion.learnmore']}}
产品信息
12016-1-AP
种属反应
已发表种属
宿主/亚型
分类
类型
抗原
偶联物
形式
浓度
规格
纯化类型
保存液
内含物
保存条件
运输条件
产品详细信息
Immunogen sequence: MDADEGQDM SQVSGKESPP VSDTPDEGDE PMPIPEDLST TSGGQQSSKS DRVVASNVKV ETQSDEENGR ACEMNGEECA EDLRMLDASG EKMNGSHRDQ GSSALSGVGG IRLPNGKLKC DICGIICIGP NVLMVHKRSH TGERPFQCNQ CGASFTQKGN LLRHIKLHSG EKPFKCHLCN YACRRRDALT GHLRTHSVIK EETNHSEMAE DLCKIGSERS LVLDRLASNV AKRKSSMPQK FLGDKGLSDT PYDSSASYEK ENEMMKSHVM DQAINNAINY LGAESLRPLV QTPPGGSEVV PVIS (1-303 aa encoded by BC018349)
靶标信息
DNA-binding protein IKAROS functions in the specification and the maturation of the T lymphocyte. It also interacts with a critical control element in the terminal deoxynucleotidyl transferase promoter as well as with the promoters for other genes expressed during early stages of B-cell and T-cell development.
仅用于科研。不用于诊断过程。未经明确授权不得转售。
生物信息学
蛋白别名: CLL-associated antigen KW-6; DNA-binding protein Ikaros; hIk-1; Ikaros family zinc finger protein 1; Ikaros zinc finger protein; zinc finger protein subfamily 1A 1; DNA-binding protein Ikaros; CLL-associated antigen KW-6; Ikaros family zinc finger protein 1; lymphoid transcription factor LyF-1; lymphocyte-restricted zinc finger DNA binding protein; Lymphoid transcription factor LyF-1; predicted protein of HQ0758; protein phosphatase 1, regulatory subunit 92; unnamed protein product; zinc finger protein, subfamily 1A, 1 (Ikaros); zinc finger transcription factor
基因别名: 5832432G11Rik; CVID13; hlk-1; Hs.54452; IK1; IKAROS; IKZF1; LyF-1; LYF1; mKIAA4227; PPP1R92; PRO0758; RGD1562979; Zfpn1a1; ZNFN1A1
UniProt ID: (Human) Q13422
Entrez Gene ID: (Human) 10320, (Mouse) 22778, (Rat) 305501